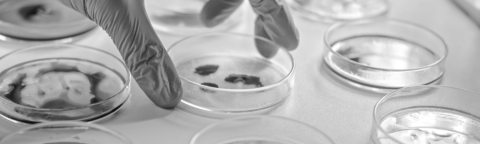
obrázek článku

Thomas je přední výrobce produktů pro řízení průtoku včetně kompresorů, vakuových a kapalinových čerpadel. Díky široké škále tlakových, vakuových a kapalinových technologií slouží naše řešení výrobcům OEM v různých průmyslových odvětvích, včetně lékařství, laboratoří, životního prostředí a dalších.

Poptávky, technické dotazy k výrobkům a náhradním dílům, výběr příslušenství:
605 213 713Objednávky, dotazy k objednávkám, platbám, přepravnému:
725 983 903